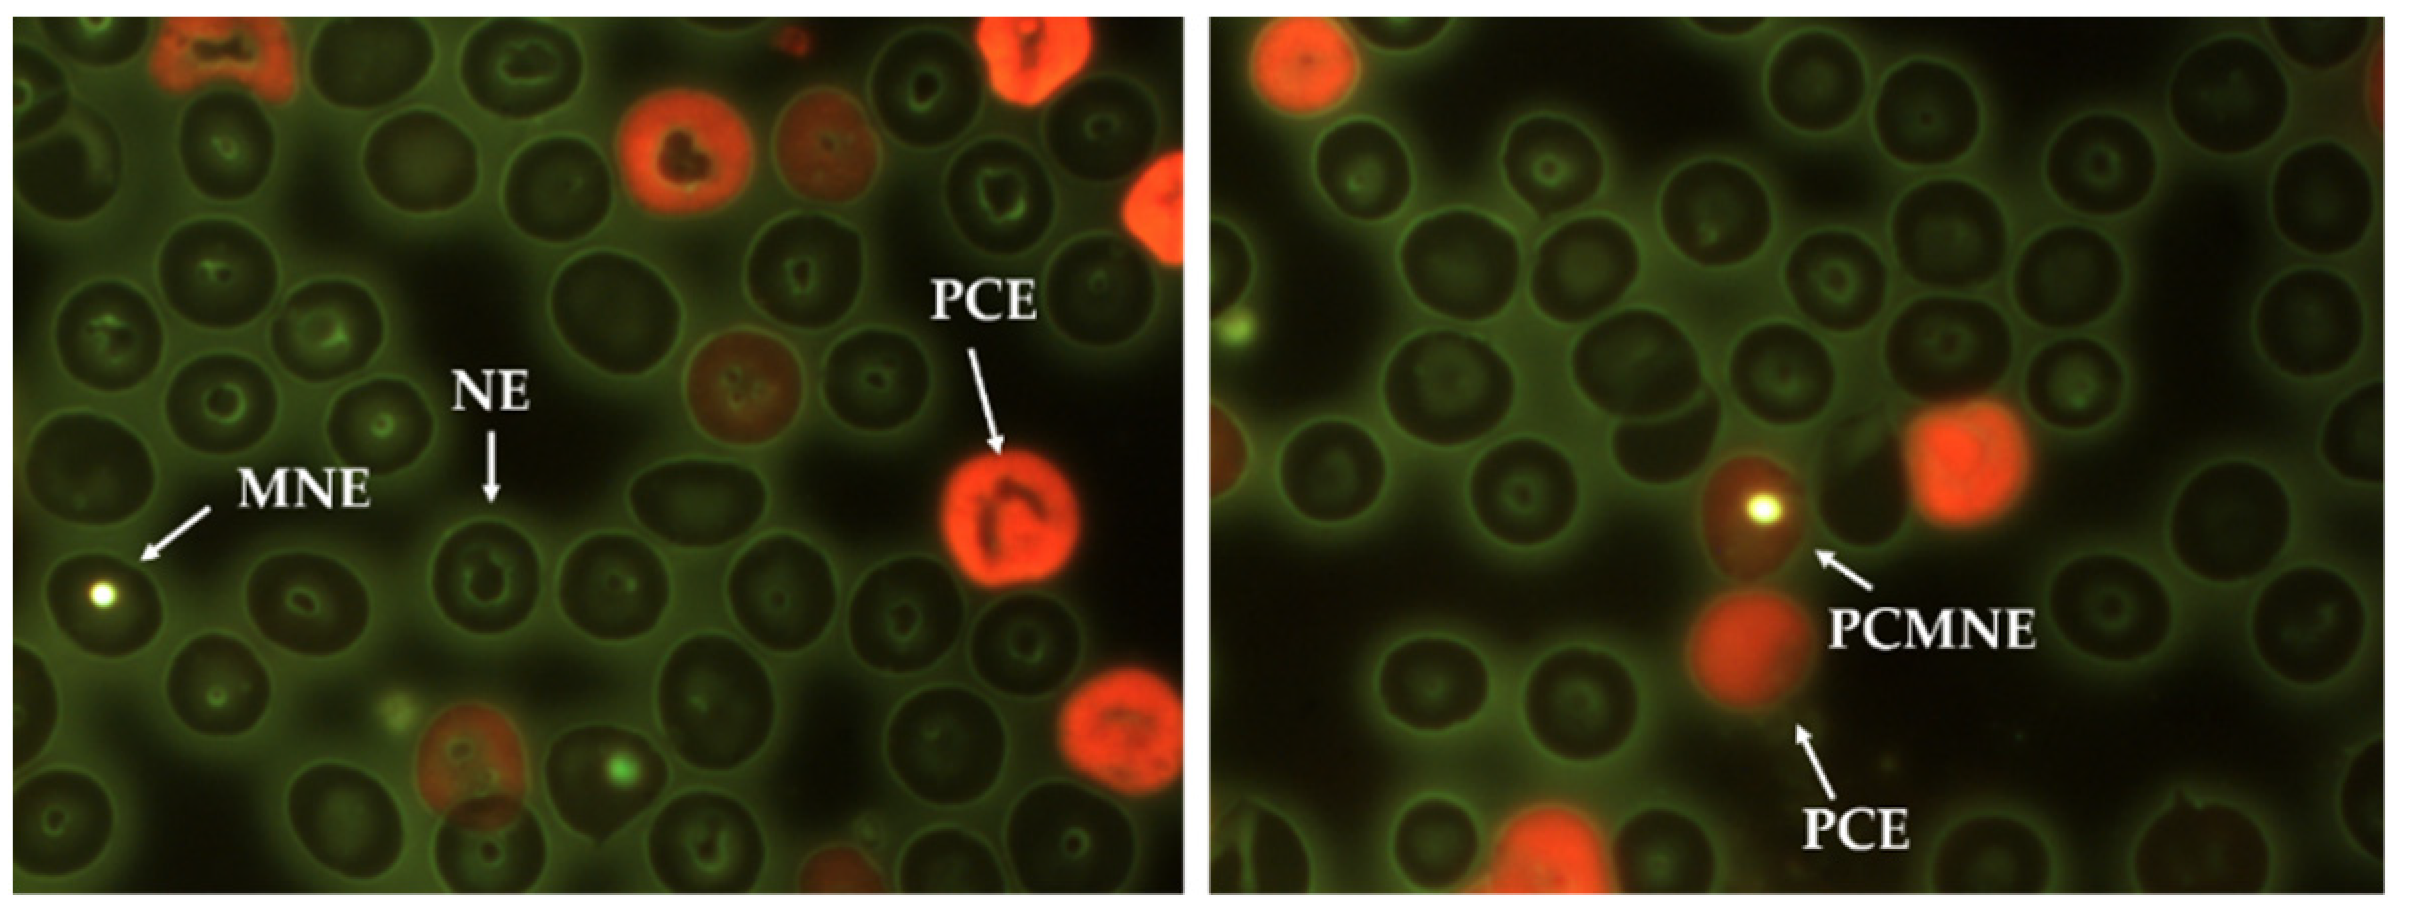
Nanomaterials 11 02096 g002 Nanomaterials 11 02096 g002

AgNPs Argovit™ Modulates Cyclophosphamide-Induced Genotoxicity on Peripheral Blood Erythrocytes In Vivo
Abstract
1. Introduction
2. Materials and Methods
2.1. AgNPs and Chemical Compounds
2.1.1. Physicochemical Properties of AgNPs
2.1.2. Evaluated Compounds
- Distilled water (200 µL, i.p.).
2.2. Animals and Collected Samples
2.2.1. BALB/c Mice
2.2.2. Work Groups
2.2.3. Sample Collection and Processing
2.3. Data Analysis
3. Results
3.1. General Toxicity
3.2. Myelosuppression-Cytotoxicity
3.3. Genotoxicity
4. Discussion
5. Conclusions
Supplementary Materials
Author Contributions
Funding
Institutional Review Board Statement
Informed Consent Statement
Data Availability Statement
Acknowledgments
Conflicts of Interest
References
- Kahan, D.M. Nanotechnology and society: The evolution of risk perceptions. Nat. Nanotechnol. 2009, 4, 705–706. [Google Scholar] [CrossRef]
- Nallanthighal, S.; Chan, C.; Bharali, D.J.; Mousa, S.A.; Vásquez, E.; Reliene, R. Particle coatings but not silver ions mediate genotoxicity of ingested silver nanoparticles in a mouse model. NanoImpact 2017, 5, 92–100. [Google Scholar] [CrossRef]
- Bacchetta, C.; Ale, A.; Simoniello, M.F.; Gervasio, S.; Davico, C.; Rossi, A.S.; Desimone, M.F.; Poletta, G.; López, G.; Monserrat, J.M.; et al. Genotoxicity and oxidative stress in fish after a short-term exposure to silver nanoparticles. Ecol. Indic. 2017, 76, 230–239. [Google Scholar] [CrossRef]
- Patlolla, A.K.; Hackett, D.; Tchounwou, P.B. Genotoxicity study of silver nanoparticles in bone marrow cells of Sprague–Dawley rats. Food Chem. Toxicol. 2015, 85, 52–60. [Google Scholar] [CrossRef] [PubMed]
- Fewtrell, L.; Majuru, B.; Hunter, P.R. A re-assessment of the safety of silver in household water treatment: Rapid systematic review of mammalian in vivo genotoxicity studies. Environ. Health 2017, 16, 66. [Google Scholar] [CrossRef]
- Flores-López, L.Z.; Espinoza-Gómez, H.; Somanathan, R. Silver nanoparticles: Electron transfer, reactive oxygen species, oxidative stress, beneficial and toxicological effects. Mini review. J. Appl. Toxicol. 2019, 39, 16–26. [Google Scholar] [CrossRef]
- Xu, L.; Li, X.; Takemura, T.; Hanagata, N.; Wu, G.; Chou, L.L. Genotoxicity and molecular response of silver nanoparticle (NP)-based hydrogel. J. Nanobiotechnol. 2012, 10, 16. [Google Scholar] [CrossRef]
- Ge, L.; Li, Q.; Wang, M.; Ouyang, J.; Li, X.; Xing, M.M.Q. Nanosilver particles in medical applications: Synthesis, performance, and toxicity. Int. J. Nanomed. 2014, 9, 2399–2407. [Google Scholar] [CrossRef]
- Gherasim, O.; Puiu, R.A.; Bîrca, A.C.; Burduşel, A.C.; Grumezescu, A.M. An updated review on silver nanoparticles in biomedicine. Nanomaterials 2020, 10, 2318. [Google Scholar] [CrossRef] [PubMed]
- Sánchez-López, E.; Gomes, D.; Esteruelas, G.; Bonilla, L.; Lopez-Machado, A.L.; Galindo, R.; Cano, A.; Espina, M.; Ettcheto, M.; Camins, A.; et al. Metal-based nanoparticles as antimicrobial agents: An overview. Nanomaterials 2020, 10, 292. [Google Scholar] [CrossRef]
- Glotov, A.G.; Glotova, T.I.; Sergeev, A.A.; Belkina, T.V.; Sergeev, A.N. Antiviral activity of different drugs in vitro against viruses of bovine infectious rhinotracheitis and bovine diarrhea. Vopr. Virusol. 2004, 49, 43–46. [Google Scholar] [PubMed]
- Semenov, F.V.; Fidarova, K.M. The treatment of the patients presenting with chronic inflammation of the trepanation cavity with a preparation containing silver nanoparticles following sanitation surgery of the open type. Vestn. Otorinolaringol. 2012, 6, 117–119. [Google Scholar]
- Bogdanchikova, N.; Vázquez-Muñoz, R.; Huerta-Saquero, A.; Peña-Jasso, A.; Aguilar-Uzcanga, G.; Picos-Díaz, P.L.; Pestryakov, A.; Burmistrov, V.A.; Martynyuk, O.; Luna-Vázquez-Gómez, R.; et al. Silver nanoparticles composition for treatment of distemper in dogs. Int. J. Nanotechnol. 2016, 13, 227–237. [Google Scholar] [CrossRef]
- Borrego, B.; Lorenzo, G.; Mota-Morales, J.D.; Almanza-Reyes, H.; Mateos, F.; López-Gil, E.; de la Losa, N.; Burmistrov, V.A.; Pestryakov, A.N.; Brun, A.; et al. Potential application of silver nanoparticles to control the infectivity of Rift Valley fever virus in vitro and in vivo. Nanomed. Nanotechnol. Biol. Med. 2016, 12, 1185–1192. [Google Scholar] [CrossRef]
- Kalmantaeva, O.V.; Firstova, V.V.; Potapov, V.D.; Zyrina, E.V.; Gerasimov, V.N.; Ganina, E.A.; Burmistrov, V.A.; Borisov, A.V. Silver-nanoparticle exposure on immune system of mice depending on the route of administration. Nanotechnol. Russ. 2014, 9, 571–576. [Google Scholar] [CrossRef]
- Juarez-Moreno, K.; Gonzalez, E.; Girón-Vazquez, N.; Chávez-Santoscoy, R.; Mota-Morales, J.; Perez-Mozqueda, L.; Garcia-Garcia, M.; Pestryakov, A.; Bogdanchikova, N. Comparison of cytotoxicity and genotoxicity effects of silver nanoparticles on human cervix and breast cancer cell lines. Hum. Exp. Toxicol. 2017, 36, 931–948. [Google Scholar] [CrossRef]
- Ruiz-Ruiz, B.; Arellano-García, M.E.; Radilla-Chávez, P.; Salas-Vargas, D.S.; Toledano-Magaña, Y.; Casillas-Figueroa, F.; Luna Vazquez-Gomez, R.; Pestryakov, A.; García-Ramos, J.C.; Bogdanchikova, N. Cytokinesis-block micronucleus assay using human lymphocytes as a sensitive tool for cytotoxicity/genotoxicity evaluation of AgNPs. ACS Omega 2020, 5, 12005–12015. [Google Scholar] [CrossRef] [PubMed]
- Casillas-Figueroa, F.; Arellano-García, M.E.; Leyva-Aguilera, C.; Ruíz-Ruíz, B.; Vázquez-Gómez, R.L.; Radilla-Chávez, P.; Chávez-Santoscoy, R.A.; Pestryakov, A.; Toledano-Magaña, Y.; García-Ramos, J.C.; et al. Argovit™ silver nanoparticles effects on allium cepa: Plant growth promotion without cyto genotoxic damage. Nanomaterials 2020, 10, 1386. [Google Scholar] [CrossRef]
- Sommer, S.; Buraczewska, I.; Kruszewski, M. Micronucleus assay: The state of art, and future directions. Int. J. Mol. Sci. 2020, 21, 1534. [Google Scholar] [CrossRef]
- Zúñiga-González, G.; Torres-Bugarín, O.; Zamora-Perez, A.; Gómez-Meda, B.C.; Ramos Ibarra, M.L.; Martínez-González, S.; González-Rodríguez, A.; Luna-Aguirre, J.; Ramos-Mora, A.; Ontiveros-Lira, D.; et al. Differences in the number of micronucleated erythrocytes among young and adult animals including humans—Spontaneous micronuclei in 43 species. Mutat. Res. Genet. Toxicol. Environ. Mutagen. 2001, 494, 161–167. [Google Scholar] [CrossRef]
- Araujo-Espino, D.I.; Zamora-Perez, A.L.; Zúñiga-González, G.M.; Gutiérrez-Hernández, R.; Morales-Velazquez, G.; Lazalde-Ramos, B.P. Genotoxic and cytotoxic evaluation of Jatropha dioica Sessé ex Cerv. by the micronucleus test in mouse peripheral blood. Regul. Toxicol. Pharmacol. 2017, 86, 260–264. [Google Scholar] [CrossRef] [PubMed]
- OECD/OCDE. OECD 474 Guideline for the Testing of Chemicals: Mammalian Erythrocyte Micronucleous Test; OECD Publishing: Paris, France, 2016. [Google Scholar]
- Adhikari, A. Micronuclei (MN), an important cancer biomarker. Edelweiss Cancer Open Access 2019, 37–42. [Google Scholar] [CrossRef]
- Ponticelli, C.; Escoli, R.; Moroni, G. Does cyclophosphamide still play a role in glomerular diseases? Autoimmun. Rev. 2018, 17, 1022–1027. [Google Scholar] [CrossRef]
- Velásquez, C.A.; González, M.; Berrouet, M.C.; Jaramillo, N. Cardiotoxicidad inducida por la quimioterapia desde las bases moleculares hasta la perspectiva clínica. Rev. Colomb. Cardiol. 2016, 23, 104–111. [Google Scholar] [CrossRef]
- Yilmaz, N.; Emmungil, H.; Gucenmez, S.; Ozen, G.; Yildiz, F.; Balkarli, A.; Kimyon, G.; Coskun, B.N.; Dogan, I.; Pamuk, O.N.; et al. Incidence of cyclophosphamide-induced urotoxicity and protective effect of mesna in rheumatic diseases. J. Rheumatol. 2015, 42, 1661–1666. [Google Scholar] [CrossRef] [PubMed]
- Naghshvar, F.; Abianeh, S.M.; Ahmadashrafi, S.; Hosseinimehr, S.J. Chemoprotective effects of carnosine against genotoxicity induced by cyclophosphamide in mice bone marrow cells. Cell Biochem. Funct. 2012, 30, 569–573. [Google Scholar] [CrossRef] [PubMed]
- Valenzuela-Salas, L.M.; Girón-Vázquez, N.G.; García-Ramos, J.C.; Torres-Bugarín, O.; Gómez, C.; Pestryakov, A.; Villarreal-Gómez, L.J.; Toledano-Magaña, Y.; Bogdanchikova, N. Antiproliferative and antitumor effect of non-genotoxic silver nanoparticles on melanoma models. Oxid. Med. Cell. Longev. 2019, 2019, 4528241. [Google Scholar] [CrossRef]
- Hayashi, M.; MacGregor, J.T.; Gatehouse, D.G.; Blakey, D.H.; Dertinger, S.D.; Abramsson-Zetterberg, L.; Krishna, G.; Morita, T.; Russo, A.; Asano, N.; et al. In vivo erythrocyte micronucleus assay. Mutat. Res. Toxicol. Environ. Mutagen. 2007, 627, 10–30. [Google Scholar] [CrossRef]
- Torres-Bugarín, O.; Zavala-Aguirre, J.L.; Gómez-Rubio, P.; Buelna-Osben, H.R.; Zúñiga-González, G.; Gómez, M.G.-U. Potential fish species as genotoxicity biomarkers at lake “La Alberca”, Michoacan, Mexico. Hidrobiológica 2007, 17, 75–81. [Google Scholar]
- Krishna, G.; Hayashi, M. In vivo rodent micronucleus assay: Protocol, conduct and data interpretation. Mutat. Res. Fundam. Mol. Mech. Mutagen. 2000, 455, 155–166. [Google Scholar] [CrossRef]
- Igl, B.W.; Bitsch, A.; Bringezu, F.; Chang, S.; Dammann, M.; Frötschl, R.; Harm, V.; Kellner, R.; Krzykalla, V.; Lott, J.; et al. The rat bone marrow micronucleus test: Statistical considerations on historical negative control data. Regul. Toxicol. Pharmacol. 2019, 102, 13–22. [Google Scholar] [CrossRef]
- Gómez-Meda, B.C.; Bañales-Martínez, L.R.; Zamora-Perez, A.L.; Lemus-Varela, M.D.L.; Trujillo, X.; Sánchez-Parada, M.G.; Torres-Mendoza, B.M.; Armendáriz-Borunda, J.; Zúñiga-González, G.M. Micronucleated erythrocytes in peripheral blood from neonate rats exposed by breastfeeding to Cyclophosphamide, Colchicine, or Cytosine-Arabinoside. Biomed. Res. Int. 2016, 2016, 9161648. [Google Scholar] [CrossRef] [PubMed]
- Ochoa-Meza, A.R.; Álvarez-Sánchez, A.R.; Romo-Quiñonez, C.R.; Barraza, A.; Magallón-Barajas, F.J.; Chávez-Sánchez, A.; García-Ramos, J.C.; Toledano-Magaña, Y.; Bogdanchikova, N.; Pestryakov, A.; et al. Silver nanoparticles enhance survival of white spot syndrome virus infected Penaeus vannamei shrimps by activation of its immunological system. Fish Shellfish Immunol. 2019, 84, 1083–1089. [Google Scholar] [CrossRef] [PubMed]
- Romo-Quiñonez, C.R.; Álvarez-Sánchez, A.R.; Álvarez-Ruiz, P.; Chávez-Sánchez, M.C.; Bogdanchikova, N.; Pestryakov, A.; Mejia-Ruiz, C.H. Evaluation of a new Argovit as an antiviral agent included in feed to protect the shrimp Litopenaeus vannamei against white spot syndrome virus infection. PeerJ 2020, 2020, e8446. [Google Scholar] [CrossRef] [PubMed]
- Stephano-Hornedo, J.L.; Torres-Gutiérrez, O.; Toledano-Magaña, Y.; Gradilla-Martínez, I.; Pestryakov, A.; Sánchez-González, A.; García-Ramos, J.C.; Bogdanchikova, N. Argovit™ silver nanoparticles to fight Huanglongbing disease in Mexican limes (Citrus aurantifolia Swingle). RSC Adv. 2020, 10, 6146–6155. [Google Scholar] [CrossRef]
- Álvarez-Suárez, A.S.; Dastager, S.G.; Bogdanchikova, N.; Grande, D.; Pestryakov, A.; García-Ramos, J.C.; Pérez-González, G.L.; Juárez-Moreno, K.; Toledano-Magaña, Y.; Smolentseva, E.; et al. Electrospun fibers and sorbents as a possible basis for effective composite wound dressings. Micromachines 2020, 11, 441. [Google Scholar] [CrossRef] [PubMed]
- Vazquez-Muñoz, R.; Meza-Villezcas, A.; Fournier, P.G.J.; Soria-Castro, E.; Juarez-Moreno, K.; Gallego-Hernández, A.L.; Bogdanchikova, N.; Vazquez-Duhalt, R.; Huerta-Saquero, A. Enhancement of antibiotics antimicrobial activity due to the silver nanoparticles impact on the cell membrane. PLoS ONE 2019, 14, e0224904. [Google Scholar] [CrossRef]
- Guerra, J.D.; Sandoval, G.; Avalos-Borja, M.; Pestryakov, A.; Garibo, D.; Susarrey-Arce, A.; Bogdanchikova, N. Selective antifungal activity of silver nanoparticles: A comparative study between Candida tropicalis and Saccharomyces boulardii. Colloid Interface Sci. Commun. 2020, 37, 100280. [Google Scholar] [CrossRef]
- Valenzuela-Salas, L.M.; Blanco-Salazar, A.; Perrusquía-Hernández, J.D.; Nequiz-Avendaño, M.; Mier-Maldonado, P.A.; Ruiz-Ruiz, B.; Campos-Gallegos, V.; Arellano-García, M.E.; García-Ramos, J.C.; Pestryakov, A.; et al. New protein-coated silver nanoparticles: Characterization, antitumor and amoebicidal activity, antiproliferative selectivity, genotoxicity, and biocompatibility evaluation. Pharmaceutics 2021, 13, 65. [Google Scholar] [CrossRef]
- Spinoso-Castillo, J.L.; Chavez-Santoscoy, R.A.; Bogdanchikova, N.; Pérez-Sato, J.A.; Morales-Ramos, V.; Bello-Bello, J.J. Antimicrobial and hormetic effects of silver nanoparticles on in vitro regeneration of vanilla (Vanilla planifolia Jacks. ex Andrews) using a temporary immersion system. Plant Cell. Tissue Organ Cult. 2017, 129, 195–207. [Google Scholar] [CrossRef]
- Bello-Bello, J.J.; Chavez-Santoscoy, R.A.; Lecona-Guzmán, C.A.; Bogdanchikova, N.; Salinas-Ruíz, J.; Gómez-Merino, F.C.; Pestryakov, A. Hormetic response by silver nanoparticles on in vitro multiplication of sugarcane (Saccharum spp. Cv. Mex 69-290) using a temporary immersion system. Dose Response 2017, 15, 1–9. [Google Scholar] [CrossRef]
- Ahlberg, S.; Antonopulos, A.; Diendorf, J.; Dringen, R.; Epple, M.; Flöck, R.; Goedecke, W.; Graf, C.; Haberl, N.; Helmlinger, J.; et al. PVP-coated, negatively charged silver nanoparticles: A multi-center study of their physicochemical characteristics, cell culture and in vivo experiments. Beilstein J. Nanotechnol. 2014, 5, 1944–1965. [Google Scholar] [CrossRef] [PubMed]
- Greulich, C.; Diendorf, J.; Geßmann, J.; Simon, T.; Habijan, T.; Eggeler, G.; Schildhauer, T.A.; Epple, M.; Köller, M. Cell type-specific responses of peripheral blood mononuclear cells to silver nanoparticles. Acta Biomater. 2011, 7, 3505–3514. [Google Scholar] [CrossRef]
- Ferdous, Z.; Beegam, S.; Tariq, S.; Ali, B.H.; Nemmar, A. The in vitro effect of polyvinylpyrrolidone and citrate coated silver nanoparticles on erythrocytic oxidative damage and eryptosis. Cell. Physiol. Biochem. 2018, 49, 1577–1588. [Google Scholar] [CrossRef]
- Shokrzadeh, M.; Ahmadi, A.; Chabra, A. The potential ameliorative effects of melatonin against cyclophosphamide-induced DNA damage in murine bone marrow cells. Eur. Rev. Med. Pharmacol. Sci. 2014, 18, 605–611. [Google Scholar]
- Dobrzyńska, M.M.; Gajowik, A.; Radzikowska, J.; Lankoff, A.; Dušinská, M.; Kruszewski, M. Genotoxicity of silver and titanium dioxide nanoparticles in bone marrow cells of rats in vivo. Toxicology 2014, 315, 86–91. [Google Scholar] [CrossRef] [PubMed]
- Pang, C.; Brunelli, A.; Zhu, C.; Hristozov, D.; Liu, Y.; Semenzin, E.; Wang, W.; Tao, W.; Liang, J.; Marcomini, A.; et al. Demonstrating approaches to chemically modify the surface of Ag nanoparticles in order to influence their cytotoxicity and biodistribution after single dose acute intravenous administration. Nanotoxicology 2016, 10, 129–139. [Google Scholar] [CrossRef] [PubMed]
- Nayek, S.; De Silva, I.W.; Aguilar, R.; Lund, A.K.; Verbeck, G.F. Toxicological alterations induced by subacute exposure of silver nanoparticles in Wistar rats. J. Appl. Toxicol. 2020, 41, 972–986. [Google Scholar] [CrossRef]
- Wen, H.; Dan, M.; Yang, Y.; Lyu, J.; Shao, A.; Cheng, X.; Chen, L.; Xu, L. Acute toxicity and genotoxicity of silver nanoparticle in rats. PLoS ONE 2017, 12, e0185554. [Google Scholar] [CrossRef] [PubMed]
- Narciso, L.; Coppola, L.; Lori, G.; Andreoli, C.; Zjino, A.; Bocca, B.; Petrucci, F.; Di Virgilio, A.; Martinelli, A.; Tinari, A.; et al. Genotoxicity, biodistribution and toxic effects of silver nanoparticles after in vivo acute oral administration. NanoImpact 2020, 18, 100221. [Google Scholar] [CrossRef]
- Platonova, T.A.; Pridvorova, S.M.; Zherdev, A.V.; Vasilievskaya, L.S.; Arianova, E.A.; Gmoshinski, I.V.; Khotimchenko, S.A.; Dzantiev, B.B.; Popov, V.O.; Tutelyan, V.A. Identification of Silver Nanoparticles in the samll intestine mucosa, liver and spleen of rats by transmission Electron Microscopy. Bull. Exp. Biol. Med. 2013, 155, 236–241. [Google Scholar] [CrossRef] [PubMed]
- Buzulukov, Y.P.; Arianova, E.A.; Demin, V.F.; Safenkova, I.V.; Gmoshinski, I.V.; Tutelyan, V.A. Bioaccumulation of silver and gold nanoparticles in organs and tissues of rats studied by neutron activation analysis. Biol. Bull. 2014, 41, 255–263. [Google Scholar] [CrossRef]
- Huang, H.; Lai, W.; Cui, M.; Liang, L.; Lin, Y.; Fang, Q.; Liu, Y.; Xie, L. An evaluation of blood compatibility of silver nanoparticles. Sci. Rep. 2016, 6, 25518. [Google Scholar] [CrossRef] [PubMed]
- Fang, W.; Chi, Z.; Li, W.; Zhang, X.; Zhang, Q. Comparative study on the toxic mechanisms of medical nanosilver and silver ions on the antioxidant system of erythrocytes: From the aspects of antioxidant enzyme activities and molecular interaction mechanisms. J. Nanobiotechnol. 2019, 17, 66. [Google Scholar] [CrossRef] [PubMed]
- Cunningham, B.; Engstrom, A.M.; Harper, B.J.; Harper, S.L.; Mackiewicz, M.R. Silver nanoparticles stable to oxidation and silver ion release show size-dependent toxicity in vivo. Nanomaterials 2021, 11, 1516. [Google Scholar] [CrossRef]
- Luna-Vázquez-Gómez, R.; Arellano-García, M.E.; García-Ramos, J.C.; Radilla-Chávez, P.; Salas-Vargas, D.S.; Casillas-Figueroa, F.; Ruiz-Ruiz, B.; Bogdanchikova, N.; Pestryakov, A. Hemolysis of human erythrocytes by Argovit™ AgNPs from healthy and diabetic donors: An in vitro study. Materials 2021, 14, 2792. [Google Scholar] [CrossRef]
- Kissling, G.E.; Dertinger, S.D.; Hayashi, M.; MacGregor, J.T. Sensitivity of the erythrocyte micronucleus assay: Dependence on number of cells scored and inter-animal variability. Mutat. Res. Genet. Toxicol. Environ. Mutagen. 2007, 634, 235–240. [Google Scholar] [CrossRef][Green Version]
- Hatanaka, Y.; Kitagawa, Y.; Toyoda, Y.; Kawata, T.; Ando, N.; Kawabata, Y.; Iwai, M.; Arimura, H. Micronucleus test with cyclophosphamide using mouse peripheral blood reticulocytes. Mutat. Res. Toxicol. 1992, 278, 99–101. [Google Scholar] [CrossRef]
- Krishna, G.; Petrere, J.; Anderson, J.; Theiss, J. Use of cyclophosphamide as a positive control in dominant lethal and micronucleus assays. Mutat. Res. Mutagen. Relat. Subj. 1995, 335, 331–337. [Google Scholar] [CrossRef]
- Juarez-Moreno, K.; Mejía-Ruiz, C.H.; Díaz, F.; Reyna-Verdugo, H.; Re, A.D.; Vazquez-Felix, E.F.; Sánchez-Castrejón, E.; Mota-Morales, J.D.; Pestryakov, A.; Bogdanchikova, N. Effect of silver nanoparticles on the metabolic rate, hematological response, and survival of juvenile white shrimp Litopenaeus vannamei. Chemosphere 2017, 169, 716–724. [Google Scholar] [CrossRef]
- Üstün Alkan, F.; Esen Gürsel, F.E.; Ateş, A.; Özyürek, M.; Güçlü, K.; Altun, M. Protective effects of Salvia officinalis extract against cyclophosphamide-induced genotoxicity and oxidative stress in rats. Turk. J. Vet. Anim. Sci. 2012, 36, 646–654. [Google Scholar] [CrossRef]
- Alves, A.B.C.R.; Dos Santos, R.S.; Calil, S.D.S.; Niero, R.; Lopes, J.D.S.; Perazzo, F.F.; Rosa, P.C.P.; Andrade, S.F.; Cechinel-Filho, V.; Maistro, E.L. Genotoxic assessment of Rubus imperialis (Rosaceae) extract in vivo and its potential chemoprevention against cyclophosphamide-induced DNA damage. J. Ethnopharmacol. 2014, 153, 694–700. [Google Scholar] [CrossRef]
- Delarmelina, J.M.; Dutra, J.C.V.; Batitucci, M.D.C.P. Antimutagenic activity of ipriflavone against the DNA-damage induced by cyclophosphamide in mice. Food Chem. Toxicol. 2014, 65, 140–146. [Google Scholar] [CrossRef] [PubMed]
- Lin, S.; Hao, G.; Long, M.; Lai, F.; Li, Q.; Xiong, Y.; Tian, Y.; Lai, D. Oyster (Ostrea plicatula Gmelin) polysaccharides intervention ameliorates cyclophosphamide—Induced genotoxicity and hepatotoxicity in mice via the Nrf2—ARE pathway. Biomed. Pharmacother. 2017, 95, 1067–1071. [Google Scholar] [CrossRef]
- Carneiro, C.C.; de Moraes-Filho, A.V.; Fernandes, A.S.; da Costa Santos, S.; de Melo e Silva, D.; Chen, L.C. Cytotoxic and chemopreventive effects of gemin D against different mutagens using in vitro and in vivo assays. Anticancer. Agents Med. Chem. 2017, 17, 712–718. [Google Scholar] [CrossRef]
- Da Silva Lima, D.C.; Do Vale, C.R.; Veéras, J.H.; Bernardes, A.; Peérez, C.N.; Chen-Chen, L. Absence of genotoxic effects of the chalcone (E)-1-(2-hydroxyphenyl)-3-(4-methylphenyl)-prop-2-en-1-one) and its potential chemoprevention against DNA damage using in vitro and in vivo assays. PLoS ONE 2017, 12, e0171224. [Google Scholar] [CrossRef]
- López Nigro, M.M.; Peroni, R.N.; Ayllón-Cabrera, I.; Schiariti Lampropulos, V.E.; Roma, M.I.; Carballo, M.A. In vivo antigenotoxic activity of Diplotaxis tenuifolia against cyclophosphamide-induced DNA damage: Relevance of modulation of hepatic ABC efflux transporters. Mutat. Res. Genet. Toxicol. Environ. Mutagen. 2018, 836, 72–78. [Google Scholar] [CrossRef]
- Melek, F.R.; Aly, F.A.; Kassem, I.A.A.; Abo-Zeid, M.A.M.; Farghaly, A.A.; Hassan, Z.M. Three further triterpenoid saponins from Gleditsia caspica fruits and protective effect of the total saponin fraction on cyclophosphamide-induced genotoxicity in mice. Z. Fur Naturforsch. Sect. C J. Biosci. 2015, 70, 31–37. [Google Scholar] [CrossRef] [PubMed]
- Carneiro, C.C.; da Costa Santos, S.; de Souza Lino, R.; Bara, M.T.F.; Chaibub, B.A.; de Melo Reis, P.R.; Chaves, D.A.; da Silva, A.J.R.; Silva, L.S.; de Melo e Silva, D.; et al. Chemopreventive effect and angiogenic activity of punicalagin isolated from leaves of Lafoensia pacari A. St.-Hil. Toxicol. Appl. Pharmacol. 2016, 310, 1–8. [Google Scholar] [CrossRef]
- Batista, N.J.C.; de Carvalho Melo Cavalcante, A.A.; de Oliveira, M.G.; Medeiros, E.C.N.; Machado, J.L.; Evangelista, S.R.; Dias, J.F.; dos Santos, C.E.I.; Duarte, A.; da Silva, F.R.; et al. Genotoxic and mutagenic evaluation of water samples from a river under the influence of different anthropogenic activities. Chemosphere 2016, 164, 134–141. [Google Scholar] [CrossRef]

| Model | Shape | Size (nm) | Hydrodynamic Diameter (nm) | Silver Content | Coating | Z Potential (mV) | Biomarker | Administration Scheme | Observed Effect | References |
|---|---|---|---|---|---|---|---|---|---|---|
| Mouse (male) BALB/c Five–six-weeks-old | Spheroidal | 35 | 75 | 1.2% w/w | PVP | −15 | MN peripheral blood erythrocytes | OA 6 mg/kg/daily/3 days | Neither cytotoxic nor acute genotoxic damage. Cumulative genotoxicity | This work |
| Mouse (C57BL/6J pun/pun) | ND | 32 ± 0.7 | ND | ND | PVP | ND | Oxidative damage MN frequency staining with Giemsa | OA 4 mg/kg daily/7 days | Neither oxidative damage nor MN frequency increase | [2] |
| Rats Wistar 14-weeks-old | Spheroidal | 20 ± 5 | 20–77.29 ± 1.4 | ND | ND | 33.6 | MN bone marrow | IV single dose AgNPs 20 nm: 5 and 10 mg/kg AgNPs 20 nm: 10 mg/kg | Genotoxicity after 24 h of exposure (p < 0.5) | [47] |
| 200 ± 50 | 200–333.12 ± 2.5 | ND | ND | 37.5 | IV single dose AgNPs 200 nm: 5 mg/kg | Genotoxicity after 24 h of exposure (p < 0.5) | [47] | |||
| Mouse BALB/c eight-weeks-old | 28.7 | 36.2 | 20 µg | PVP | 22.1 | Flow cytometry | IV 5 µg/mL/ during 24 h | No effect observed | [48] | |
| Rats (male) Wistar six-weeks-old | ND | ND | ND | ND | ND | ND | MN Bone marrow | Inhalation/4 h per day/200 parts per billion/5 days | Cytotoxicity and genotoxicity | [49] |
| Rats Sprage-Dawley | Spheroidal | 6.3–629 | 1000 | 60ng/mL | ND | −22, 26.4, and 29.8 | MN Bone marrow Chromosome aberration test | IV 0.5 mg/kg 0.003 mg/kg | No effect observed | [50] |
| Mouse (male and female) CD1 Five–six-weeks-old | Spheroidal | 20.7 ± 3.0 | 23.5 ±0.7 | ND | ND | −16 | Comet assay MN lymphocytes from murine spleen | OA 50, 150, and 300 mg/kg/per day/3 days | Neither oxidative damage nor MN frequency increase | [51] |
Publisher’s Note: MDPI stays neutral with regard to jurisdictional claims in published maps and institutional affiliations. |
© 2021 by the authors. Licensee MDPI, Basel, Switzerland. This article is an open access article distributed under the terms and conditions of the Creative Commons Attribution (CC BY) license (https://creativecommons.org/licenses/by/4.0/).
Share and Cite
Castañeda-Yslas, I.Y.; Torres-Bugarín, O.; García-Ramos, J.C.; Toledano-Magaña, Y.; Radilla-Chávez, P.; Bogdanchikova, N.; Pestryakov, A.; Ruiz-Ruiz, B.; Arellano-García, M.E. AgNPs Argovit™ Modulates Cyclophosphamide-Induced Genotoxicity on Peripheral Blood Erythrocytes In Vivo. Nanomaterials 2021, 11, 2096. https://doi.org/10.3390/nano11082096
Castañeda-Yslas IY, Torres-Bugarín O, García-Ramos JC, Toledano-Magaña Y, Radilla-Chávez P, Bogdanchikova N, Pestryakov A, Ruiz-Ruiz B, Arellano-García ME. AgNPs Argovit™ Modulates Cyclophosphamide-Induced Genotoxicity on Peripheral Blood Erythrocytes In Vivo. Nanomaterials. 2021; 11(8):2096. https://doi.org/10.3390/nano11082096
Chicago/Turabian StyleCastañeda-Yslas, Idalia Yazmin, Olivia Torres-Bugarín, Juan Carlos García-Ramos, Yanis Toledano-Magaña, Patricia Radilla-Chávez, Nina Bogdanchikova, Alexey Pestryakov, Balam Ruiz-Ruiz, and María Evarista Arellano-García. 2021. "AgNPs Argovit™ Modulates Cyclophosphamide-Induced Genotoxicity on Peripheral Blood Erythrocytes In Vivo" Nanomaterials 11, no. 8: 2096. https://doi.org/10.3390/nano11082096
APA StyleCastañeda-Yslas, I. Y., Torres-Bugarín, O., García-Ramos, J. C., Toledano-Magaña, Y., Radilla-Chávez, P., Bogdanchikova, N., Pestryakov, A., Ruiz-Ruiz, B., & Arellano-García, M. E. (2021). AgNPs Argovit™ Modulates Cyclophosphamide-Induced Genotoxicity on Peripheral Blood Erythrocytes In Vivo. Nanomaterials, 11(8), 2096. https://doi.org/10.3390/nano11082096

